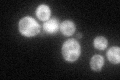
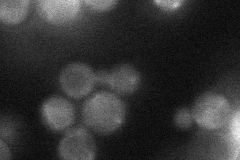
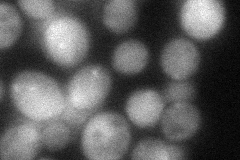
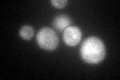

View description
Component of the CCR4-NOT transcriptional complex, which is involved in regulation of gene expression; component of the major cytoplasmic deadenylase, which is involved in mRNA poly(A) tail shortening
Localization:
Intensity:
Fold change:
Significance:
-
C’ GFP library in SD
cytosol56.78 -
N' NOP1pr-GFP in SD

cytosol114.488 -
N' TEF2pr-mCherry in SD

cytosol127.662 -
N' NATIVEpr-GFP in SD
cytosol26.6601 -
N' TEF2pr-VC and Cyto-VN in SD
cytosol52.7526 -
C’ GFP library in SD+DTT
cytosol53.30.93No -
C’ GFP library in SD+H2O2

cytosol63.351.11No -
C’ GFP library in Starvation Media

cytosol60.521.06No -
C’ GFP library on the background of Pup2-DaMP

cytosol -
C’ GFP library on the background of CCT mutant

cytosol62.18231.09509No
